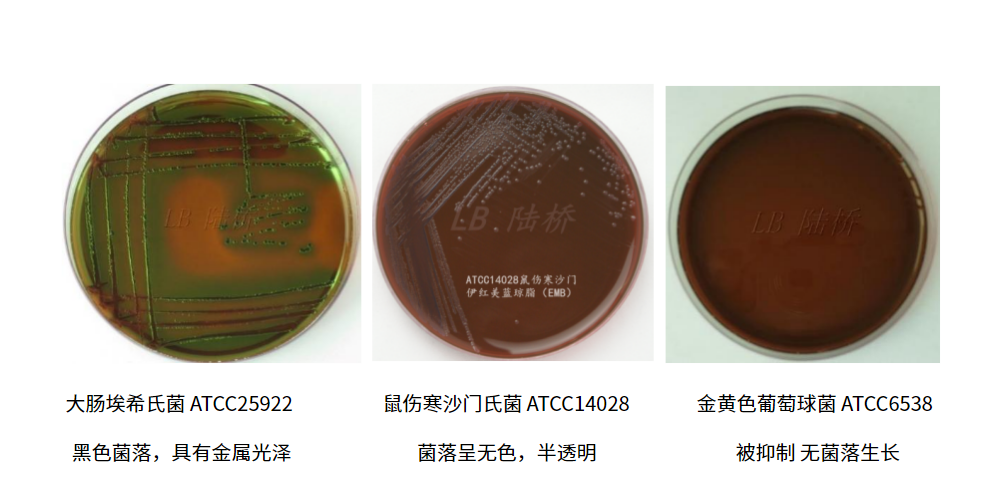
大腸埃希氏菌的選擇性分離培養(yǎng)基——伊紅美藍瓊脂(EMB) 大腸埃希氏菌的選擇性分離培養(yǎng)基——伊紅美藍瓊脂(EMB)

大腸埃希氏菌廣泛存在于人和溫血動物的腸道中, 能夠在44.5℃發(fā)酵乳糖產酸產氣, IMViC(靛基質���、 甲基紅、 VP試驗、 檸檬酸鹽)生化試驗為++--或-+--的革蘭氏陰性桿菌����。 以此作為糞便污染指標來評價食品的衛(wèi)生狀況��,推斷食品中腸道致病菌污染的可能性���。
大腸埃希氏菌的生理特性
大腸埃希氏菌為革蘭氏陰性短桿菌�,無芽胞�,需氧或兼性厭氧�����,能發(fā)酵乳糖��,周生鞭毛����,能運動。

細菌微生物矢量插圖橫斷面標記圖

革蘭氏染色鏡檢圖
大腸埃希氏菌檢測中出鏡率最高的選擇性分離培養(yǎng)基—伊紅美藍瓊脂(EMB)
伊紅美藍瓊脂(EMB)作為大腸埃希氏菌的選擇性分離培養(yǎng)基廣泛應用于各行業(yè)的標準中���。如:GB 4789.6-2016《食品安全國家標準 食品微生物學檢驗 致瀉大腸埃希氏菌檢驗》��;GB 4789.38-2016《食品安全國家標準 食品微生物學檢驗大腸埃希氏菌計數》;美國食品藥品管理局(FDA)《細菌分析手冊》第4章大腸菌群和大腸桿菌計數(BAM 4: Enumeration of Escherichia coli and the Coliform Bacteria)和第4A章致瀉大腸埃希氏菌檢測(BAM Chapter 4A: Diarrheagenic Escherichia coli )���;
EMB的基本原理
原理:
蛋白胨在培養(yǎng)基中作為營養(yǎng)物質提供菌體細胞生長所需要的氮源及其它營養(yǎng)元素�����;乳糖為提供菌體細胞生長提供可發(fā)酵的糖類��;磷酸氫二鉀是緩沖劑;伊紅與美藍同時作為抑制性(抑制革蘭氏陽性菌的生長)和指示劑,在酸性條件下���,二者結合形成黑色沉淀�;瓊脂為凝固劑。
伊紅為酸性染料,美藍為堿性染料��,細菌分解乳糖產酸時,如大腸埃希氏菌���,細菌帶正電荷����,可以與帶負電的酸性染料伊紅結合染上伊紅的顏色�����,再與美藍反應而形成黑色菌落;如果細菌因產堿性物質較多���,帶負電荷時與帶正電的堿性染料美藍結合使得菌落呈藍色。細菌產酸量較大時,染料可析出結晶形成綠色金屬光澤���。

EMB的質量控制
培養(yǎng)基質控(參照GB4789.28-2013附錄E)

用1μL接種環(huán)將新鮮菌液劃線接種EMB瓊脂平板���,36℃±1℃培養(yǎng)18h-24h�����。
下面我們再展示一下不同菌株在EMB平板上的形態(tài)特征����??筛爬橐韵氯悾?/span>
分解乳糖的典型菌落為中心紫黑色帶或不帶金屬光澤��。

不分解乳糖的菌落為無色或淡粉色�����。

有的細菌因產生堿性物質較多��,而出現藍色菌落。

參考文獻:
蔣原.食源性病原微生物檢測技術圖譜[M]. 北京:科學出版社, 2019 166-168
王欽升 周正明 高屹.實用醫(yī)學培養(yǎng)基手冊[M]. 北京:人名軍醫(yī)出版社, 1993?162-163
陳彥長?牛春麗 李謹 李桂生.常見細菌及檢驗實用技術[M]. 北京:中國科學技術出版社, 2004 9-14
GB 4789.6-2016 食品安全國家標準 食品微生物學檢驗 致瀉大腸埃希氏菌檢驗��;
GB 4789.38-2016食品安全國家標準 食品微生物學檢驗大腸埃希氏菌計數����;